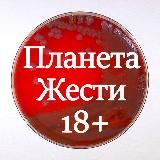
Планета жести 18+

- 交易所
- 沙盒
- 已删除
- GIF 和视频892
- IT856
- SMM7280
- Telegram8631
- 汽车和摩托车6338
- 作者博客2953
- 赌博614
- 笑话155
- 动漫841
- 活动228
- 商业与金融17073
- 博主33562
- 军事257
- 全部10713
- 星座和神秘学6146
- 暗网807
- 设计5831
- 成人2625
- 男士628
- 为家长5950
- 高考和考试9039
- 健康8941
- 游戏16526
- Instagram1957
- 艺术6081
- 目录230
- 冠状病毒235
- Красота и мода19391
- 加密货币15891
- 烹饪8605
- 生活技巧201
- 语言学3840
- 文学7547
- 商店和销售16851
- 医学6545
- 移动1666
- 音乐16388
- 科学与技术10268
- 房地产1749
- 新闻39805
- 教育14830
- 单行147
- 播客154
- 偷听202
- 知识性内容1531
- 政治15507
- 色情内容 18+25441
- 自然与动物5887
- 预测和投注10071
- 代理41
- 心理学13744
- 旅行11293
- 其他177271
- 区域1715
- 宗教9989
- 手工艺2279
- 服务168
- 泄漏646
- 软件202
- 体育10584
- 贴纸193
- 建筑与维修4964
- 远程工作7148
- 女权-BLM171
- 事实882
- 电影与电视剧12074
- 照片11249
- 免费和折扣1496
- 引用9039
- 聊天70888
- 震撼内容1740
- 生态117
- 经济9585
- 幽默14677
- 法律2843
- 🇦🇲 亚美尼亚频道206
- 🇦🇿 阿塞拜疆频道218
- 🇧🇾 白俄罗斯频道1015
- 🇬🇪 格鲁吉亚频道47
- 🇰🇬 吉尔吉斯斯坦频道625
- 🇰🇿 哈萨克斯坦频道728
- 🇲🇩 摩尔多瓦频道48
- 🇹🇯 塔吉克斯坦频道583
- 🇺🇦 乌克兰频道12571
- 🇺🇿 乌兹别克斯坦频道9578
Telegram频道类别为“全部”

172−1
хуй знает: полумертвый недоживой канал. вп не вижу смысла вам делать. avtor - @alianrobyn 👽 shit ot avtora - @grentezi_fechka ☕️ lampovij chat gde inogda cheta pishut no ne fuckt - https://t.me/joinchat/xjoqccLSCLczMjVi 💫

172−3
Наш Бот для Заработка👇👇👇 @ZentaraMoney_bot Канал с выплатами💰 @ZentaraINFO Заказ Рекламы🕵️Рассылка✍ @astik_deweloper Чат для общения🍾 @Zentara_Chat

172
❄️Welcome❄️ 🇯🇵Tik Tok videos🇯🇵 For questions @World_of_kpopbot ❦ 🎋Employees: @aesthetics_kpop✮ @korea_tiktok✵ @china_tiktok♱ @tiktok_gensh

172−3
💚 Wine Casino Montenegro ❤️ Самое лучшее вино — это вино, которое больше всего нравится тому, кто его пьет! 🎓 Винная Школа 🍷Винные мастер-классы

172−1
Гоняю автостопом с дроном в рюкзаке, пишу тексты и ищу, как приносить этим пользу.

172
только оригинальная продукция Более 8 лет на рынке iPhone 📱 iPad 📱 AirPods 🎧 Apple watch ⌚️ Apple техника| Продажа|обмен|Trade In|скупка

171
Канал игры Умный Доход. Подробнее об игре: http://goodsite.pro Призовой фонд 1 млн. рублей Контакт: @vitalyapilat @artsitnov
171+21
Много разной видеожести со всех уголков планеты: аварии, происшествия, стихийные бедствия, драки, случайные смерти и многое другое. По всем вопросам обращаться: @lakusha_5, @mercuso4

171+1
КОНДИТЕРСКАЯ ШКОЛА КРАСНОДАР https://www.vip-masters.ru/schedule/krasnodar/ VIP-Masters 🌏Международная кулинарная школа @alexander_kislitsyn Курсы для начинающих и профессионалов. ⬇️Расписание курсов на нашем сайте⬇️

171−1
Приверженец адекватной медицины) Честно и без лишнего о женском здоровье 👌🏻 Гинекология, Эндокринология, Репродуктология, Генетика 89298269193

171−1
Аренда строительного инструмента и оборудования ⚒️⚙️ Здесь забывают о компромиссах и выбирают только современный, мощный и удобный инвентарь.👌 Если вы привыкли ценить своё время, деньги и результат — вы по адресу!😉 ☎️8 (846) 200-16-60 🌐www.profrent.su
如何在TgramSearch中搜索频道
由于 Telegram 应用程序的搜索返回的结果有限,因此更方便使用第三方解决方案来搜索电报频道。
TgramSearch 允许搜索包含超过 700000 个电报频道的数据库,最重要的是,获取满足您查询条件的完整频道列表。
我们数据库中的电报频道列表不断更新。您可以选择感兴趣的类别或在搜索栏中输入查询。不建议输入过长的查询,查询应由一到三个单词组成,最好是一个单词。
从搜索中删除频道
请注意,网站内容是从公开来源自动填充的,除了名称、描述、链接和头像外,不存储有关Telegram频道的信息。如果您发现某个Telegram频道违反法律要求,请通过网站上菜单中提供的联系方式与我们联系。在审核投诉后,我们将从搜索中删除该Telegram频道。


















